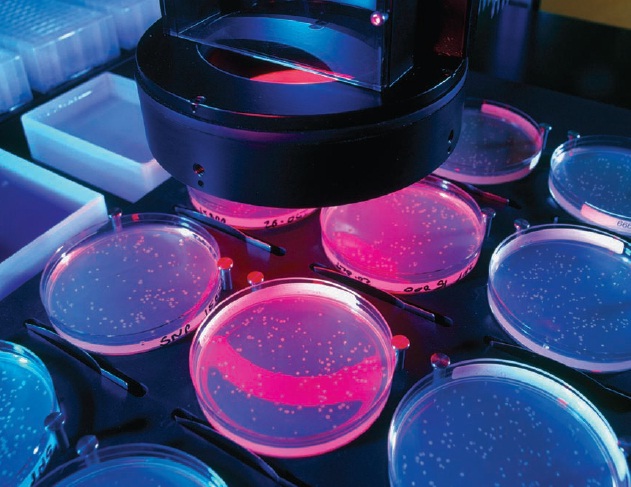

A few weeks ago David Brooks of the New York Times asked his many readers for a gift, “If you are over 70, I’d like you to write a brief report on your life so far, an evaluation of what you did well, of what you did not so well and what you learned along the way.”
His reason to make such a request was clear, “These essays will be useful to the young. Young people are educated in many ways, but they are given relatively little help in understanding how a life develops, how careers and families evolve, what are the common mistakes and the common blessings of modern adulthood.” From the many essays that he received, he tried to extract a few general life lessons. One of those many fantastic lessons took me somewhat by surprise.
Beware rumination. There were many long, detailed essays by people who are experts at self-examination. They could finely calibrate each passing emotion. But these people often did not lead the happiest or most fulfilling lives. It’s not only that they were driven to introspection by bad events. Through self-obsession, they seemed to reinforce the very emotions, thoughts and habits they were trying to escape.
Many of the most impressive people, on the other hand, were strategic self-deceivers. When something bad was done to them, they forgot it, forgave it or were grateful for it. When it comes to self-narratives, honesty may not be the best policy.
Self-development is something I am passionate about and self-examination enables me to pursue that passion. Even though I won’t call myself a self-examination expert by any length, reading the above made me question what is it that I exactly do when I work on self-development. I don’t want an obsession to improve myself to lead to an unhappy life!
But, while re-reading the paragraph, I realised that the more impressive people were ‘strategic self-deceivers’. So they selectively chose to lie to themselves about certain mistakes they made or about certain faults they had and moved on with life, eventually living an impressive life.
So was the route that I took for self-development through self-examination wrong? Not entirely. To be able to successfully deceive oneself would require one to know themselves well enough. Self-examination is then a necessary tool.
What I seem to be able to gather from this reflection is that self-examination can be a double-edged sword. It can lead to giving us the exact information we need about ourselves to enable us to build our confidence or, if over done, it can lead to reinforcing the very thoughts and habits that one wants to overcome.
But now let’s come to the more interesting part of the lesson – strategic self-deception.
Philosophers argue that one cannot, in principle, be successful at self-deception. The reason being that one can not try to convince oneself of something being false when they know that it is true. But leaving the philosophers aside, there are practical ways in which we employ self-deception, I would argue, everyday. I am ready to bet that any of you reading this is probably deceiving yourself of multiple truths right now (of course, if you are able to recognise what exactly it is that you are deceiving yourself about then you will have failed at self-deception!).
An example of self-deception is when we try to forget the pain associated with a certain event. It could be a break-up or the passing away of a loved one. We may be capable of accepting what happened and moving on but the shorter, faster route is to lie to oneself. It may also be an intermediate step in acceptance (when unsuccessful at pulling off this self-deception, we are supposed to be in denial).
Forgetting events, overcoming fears, facing danger and taking risks, all to a certain extent involve self-deception. We know, at some level, that we are very bad at analysing risks and to be able to do something risky (like bungee jumping) we have to convince ourselves that it is not as risky as it seems. In that self-deception enables the person to take risks that he would not normally.
A strategic self-deceiver is one who is able to trick themselves about the right things. Of course, knowing the right things is the more difficult part.
51.742100
-1.235487